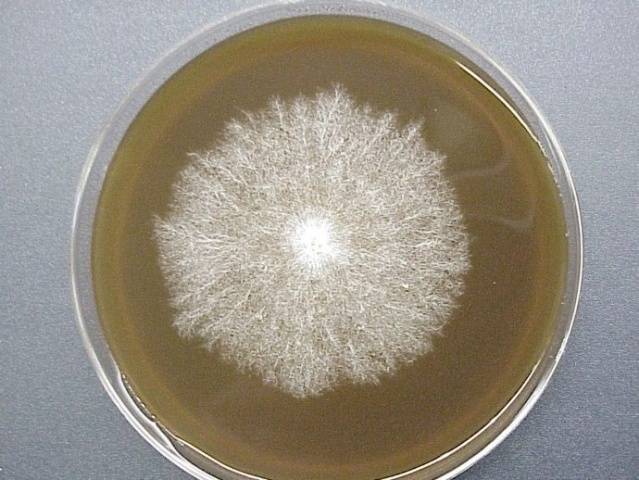

Contingut
Quan es conreen xampinyons, els costos principals, gairebé el 40%, s’associen a l’adquisició de miceli. A més, no sempre resulta d’alta qualitat. Però sabent cultivar miceli de bolets amb les teves mans, pots començar a produir-lo a casa.
Tot i la reproducció predominant dels fongs a través de les espores, també són capaços de propagació vegetativa. Aquesta propietat s’ha utilitzat durant el segle passat en la producció de bolets. La tecnologia era senzilla: després de recollir miceli en abocadors, es va plantar en sòl preparat. Tanmateix, aquest mètode no va donar grans rendiments, ja que la fructificació es va reduir per la microflora externa present al miceli. Als anys 30, es va desenvolupar un mètode cultiu de miceli de gra, que s’utilitza avui en la producció de bolets.
Mètodes de producció de miceli
El xampinyó també, com altres tipus de bolets, es reprodueix per espores. La impressió de les espores es pot veure col·locant la tapa d’un bolet madur en un full de paper amb la part inferior cap avall. En presència d’un medi nutritiu, les espores germinen, donant lloc a un nou miceli. Els xampinyons també es reprodueixen de manera excel·lent en el mètode dels teixits, quan es col·loquen en un entorn estèril amb un substrat nutritiu adequat.
En la producció de xampinyons, el cultiu d’espores i teixits de miceli i la seva selecció es duen a terme en laboratoris especials equipats amb control microbiològic, amb la capacitat de mantenir condicions estèrils, la temperatura i la humitat requerides. Però a molts cultivadors de bolets els agrada cultivar miceli de bolets a casa i ho fan amb força èxit.
Obtenció d’un medi nutritiu per al miceli
La tecnologia per cultivar miceli de bolets requereix un mitjà nutritiu adequat. És de tres tipus.
L'agar de most s'elabora amb la tecnologia següent:
- barreja most de cervesa en un volum d’un litre i uns 20 grams d’agar-agar;
- la barreja s’escalfa remenant fins que la gelea es dissolgui completament;
- els tubs estèrils s’omplen fins a un terç del seu volum amb una barreja calenta;
- els tubs, tancats amb tampons de gasa de cotó, s’esterilitzen durant 30 minuts en condicions adequades (P = 1,5 atm., t = 101 graus);
- a més, s’instal·len obliquament per augmentar la superfície del medi nutritiu, mentre que el contingut no ha de tocar el suro.
L’agar de civada es prepara a partir de components com aigua: 970 g, farina de civada: 30 g i agar-agar: 15 g. La barreja es bull durant una hora i es filtra a través d’un filtre de gasa.
L’agar de pastanaga combina 15 g d’agar-agar amb 600 g d’aigua i 400 g d’extracte de pastanaga. Després de bullir 30 minuts, la barreja es fa passar per un filtre de gasa.
Sembra de miceli de bolets
Quan el medi de cultiu dels tubs d’assaig s’endureix, comença la segona etapa d’obtenció del miceli de bolets. Al mitjà nutritiu preparat, heu de col·locar les partícules del cos del bolet, tallades amb unes pinces afilades de la tija del xampinyó. Aquesta operació s’ha de realitzar en condicions estèrils. Les pinces es poden desinfectar amb alcohol, peròxid d'hidrogen o encendre-les en una làmpada d'alcohol. En lloc de pinces, es pot utilitzar l'anomenat bucle d'inoculació. Es tracta d’una agulla de teixir d’acer amb un extrem doblegat i esmolat. És convenient per a ella obtenir peces del cos de bolets del xampinyó i afegir-les ràpidament a la proveta.
Tot el procés consta de diverses manipulacions:
- el xampinyó preparat prèviament s’ha de dividir amb cura en dues parts;
- s’ha de recollir un tros de teixit de bolets amb un dispositiu existent i baixar-lo durant un segon en una solució de peròxid d’hidrogen per a la desinfecció;
- obriu la proveta i col·loqueu ràpidament un tros de teixit de bolet xampinyó sobre el mitjà nutritiu; totes les accions s’han de dur a terme sobre la flama del cremador per evitar l’entrada de microflora patògena al medi;
- el tub es tanca immediatament amb un tap estèril que el manté també sobre la flama.
En el moment de la germinació del cultiu del fong, els tubs haurien d’estar en una habitació càlida i fosca. El miceli trigarà unes dues setmanes a omplir el medi de cultiu de la proveta. Es forma un cultiu uterí de xampinyó que es pot emmagatzemar trasplantant-lo cada any a un nou mitjà nutritiu.
Reproducció posterior del miceli
Si la tasca consisteix a multiplicar encara més el miceli de bolets, el contingut dels tubs s’introdueix en grans pots plens de substrat per 2/3. Aquest procediment també requereix condicions estèrils:
- es prepara un recés al substrat contingut al pot, després es tanca hermèticament amb una tapa metàl·lica;
- s’hi ha de fer un forat, tancat amb un endoll tou;
- preparades d'aquesta manera, les llaunes es col·loquen en autoclaus per esterilitzar durant 2 hores a pressió (2 atm);
- refredar els pots en una habitació neta;
- quan la temperatura baixa a 24 graus, podeu afegir cultiu de brou de xampinyó al substrat.
Es fan manipulacions sobre la flama del cremador. Un cop obert el tub d’assaig, se’n treu un cultiu de bolets mitjançant un bucle d’inoculació. Traieu ràpidament el suro del forat de la llauna, introduïu el miceli de bolets al recés del substrat i tanqueu el pot.
Preparació de miceli de gra
Com es fa miceli de bolets a casa amb gra? Més sovint es tria blat o civada per a aquest propòsit, però també es poden utilitzar altres cereals: sègol, ordi.
El gra sec s’omple d’aigua en una proporció de 2: 3. Per a la desinfecció, podeu afegir peròxid d’hidrogen en una proporció de 1:10 a l’aigua. La barreja es cou durant 20-30 minuts, segons la duresa del gra. S’ha de suavitzar prou, però no s’ha de coure.
Després d’escórrer l’aigua, s’ha d’assecar el gra. Una caixa de fusta on es fixa un petit ventilador és molt convenient per a aquest procediment. La caixa es tanca amb una malla metàl·lica. A la part superior de la malla s’aboca gra amb additius de guix i guix. Aquestes substàncies milloren l’estructura del gra i regulen la seva acidesa.
Els pots s’omplen amb grans secs a 2/3 del volum i s’esterilitzen a pressió. Després d’introduir-se als bancs de la cultura mare, es col·loquen en un termòstat a una temperatura de 24 graus i una humitat del 60% aproximadament.
El miceli de bolets ha de colonitzar tot el substrat del pot. El miceli de gra cultivat es pot utilitzar per a la següent sembra dels envasos. El cultiu de bolets resultant és adequat per a diversos cultius, després dels quals s’ha de renovar.
Durant el procés de colonització, els bancs haurien de revisar-se regularment. Si apareixen taques verdes o marrons o líquids amb una olor desagradable, la llauna contaminada s’ha d’esterilitzar a pressió durant 2 hores.
Per evitar que els grans s’enganxin i accelerar el creixement del miceli, cal sacsejar el pot de tant en tant.
És convenient empaquetar miceli de bolets de gra ja fet en bosses de plàstic per protegir-los de la microflora estranya. El miceli de gra es guarda fins a quatre mesos a 0-2 graus. En canvi, el miceli compost dura fins a un any.
Avantatges del cartró
Cultivar miceli de bolets a casa pot ser més fàcil i econòmic que utilitzar compost o gra. Al mateix temps, aquest material no és aliè als bolets, que també es conreen sobre serradures. La colonització de miceli xampinyó sobre cartró és ràpida i senzilla.Sovint, el cartró és encara més còmode per al miceli de bolets que el serradur, en què l’intercanvi de gasos insuficient inhibeix el desenvolupament del miceli.
Els avantatges de cultivar miceli sobre cartró són que:
- el cartró és menys susceptible a la microflora patògena;
- l'estructura ondulada del cartró proporciona un intercanvi d'aire efectiu necessari per a la respiració del miceli de bolets en creixement;
- el cartró conserva perfectament la humitat;
- no cal esterilitzar, cosa molt important;
- un argument important a favor del cartró és la seva barata i disponibilitat;
- quan s’utilitza cartró, es gasta menys temps i mà d’obra.
Caixa de bolets sobre cartró
Per obtenir el miceli de bolets, la millor opció seria el cartró ondulat marró, netejat de cola o taques de pintura. I el material de plantació es pot seleccionar entre els residus de bolets.
La tecnologia per obtenir miceli de bolets sobre cartró és molt senzilla:
- el cartró, tallat a trossos petits, es remull en aigua bullida i tèbia durant aproximadament una hora o més, i després es posa en un recipient de plàstic ampli amb forats de drenatge;
- a mà o amb un ganivet, el xampinyó s’ha de dividir en fibres;
- traient la capa superior de paper del cartró, cal estendre els trossos de xampinyó sobre la superfície ondulada, primer desinfectant-los en peròxid i tapar-los amb paper eliminat per sobre;
- compactar lleugerament les capes perquè no es formin bosses d’aire;
- per tal d’evitar la dessecació, el recipient es cobreix amb un embolcall de plàstic que s’ha de retirar cada dia i airejar-se a la plantació de cartró del miceli;
- no s’ha de deixar assecar el cartró, per tant, s’ha d’humitejar periòdicament;
- la plantació del miceli de bolets ha de ser en un lloc fosc i càlid fins que tot el cartró es converteixi en blanc del miceli cobert: el procés pot durar fins a tres mesos.
Després d’haver crescut el miceli de bolets sobre cartró, podeu plantar-lo al següent full de cartró. Sobre ell, creixerà encara més ràpid, ja que la informació sobre el medi ambient es transmet genèticament a la propera generació de bolets. Podeu utilitzar una part del miceli de cartró per obtenir una nova porció del miceli de bolets. La resta es pot utilitzar per colonitzar el substrat, per exemple, per omplir bosses amb palla pasteuritzada o serradures amb miceli de cartró. Creix bé sobre altres tipus de substrats: cafè, fulles de te, paper.
Conclusió
No és difícil cultivar miceli de bolets a casa si té paciència i s’adhereix a aquestes recomanacions. I el miceli d’alta qualitat és la clau per a una bona collita de bolets.